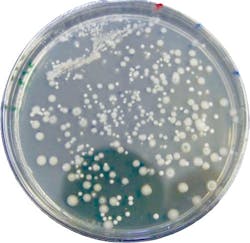
Muffe%20formaggio%20senza%20o3 Muffe%20formaggio%20senza%20o3
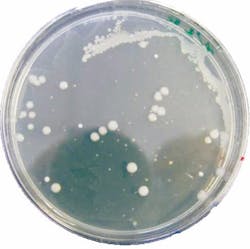
Muffe%20formaggio%20con%20o3_edit Muffe%20formaggio%20con%20o3_edit

About the author: Cristian Carboni is food market applications manager and ozone researcher for De Nora Industries. Carboni can be reached at [email protected].
According to the Agricultural Marketing Resources Center, Americans eat an average of 10 lb of cheddar and 10.6 lb of mozzarella cheese every year. Given its popularity, dairy producers consistently must focus on limiting the risks of illness-causing microorganisms during the critical storing and aging processes, while maximizing the shelf life of cheese. Meanwhile, today’s consumers seek minimal processing to their food and limited negative effects on the environment.
Recent research conducted by De Nora and Italian University proved the effectiveness of gaseous ozone treatments in meeting those criteria, especially when applied in cheese processing and aging rooms.
Tender Age
The aging period is one of the most important phases impacting cheese quality. During this phase, the compositional, structural, microbiological and sensory characteristics of the finished product forms. Temperature, humidity, and oxygenation play a critical role in many of the microbiological, chemical and physical processes that occur during the aging process, and therefore can have a major impact on product quality and spoilage.
Consumers typically are drawn to thickness, color and fungal development of a cheese’s crust, making its formation during the aging process all the more important. Functionally, the crust forms to contain the product. It protects the cheese from external agents, and adjusts the exchange of air and humidity between the cheese and the surrounding environment to control the processes occurring inside the crust. However, even expert cheese-makers struggle to control environmental factors—temperature, humidity and turning the cheese.
The cheese production and maturing environments may be sources of contamination, from the air or from the surfaces on which the product is placed (e.g., wood or plastic shelves used for aging). These elements are hard to clean with traditional systems—air for obvious reasons and wood for its porosity.
“Field tests in the dairy industry have shown that ozone treatment has significantly reduced the contamination of air and surfaces; in particular it was fundamental to sanitize the wood shelves used for aging that, despite being washed, often have high bacterial loads, due to the high porosity of the wood matrix,” said Cristian Carboni, food market and applications manager for De Nora. “But ozone’s potential does not end here. Ozone is effective in many other cases.”
The dish on the left shows mold and yeast at 230 ufc/m3. After ozone treatment (right), the mold and yeast was 23 ufc/m3.
The Ozone Effect
Ozone develops naturally from oxygen—in its pure form and its presence in the air—through an electrical discharge, and can be used as a gas or dissolved as ozonated water. Once used, ozone returns to the state of oxygen, making it sustainable for the environment, while containing and reducing consumption and costs associated with storage and transport.
Pathogenic microorganisms that can cause disease can be transported via food, water or air. Furthermore, molds and mycotoxins can develop in environments that are not sanitized. Ozone treatment is highly effective in combating bacteria, viruses, fungi, spores, biofilm, odors and mites, and reducing levels of chemical oxygen demand (COD), biochemical oxygen demand (BOD), and micropollutants. Air sanitization via gaseous ozone significantly reduces microbial load, extending shelf life. On surfaces and equipment, gaseous ozone’s deep sanitization prevents cross-contamination without residue. Results have proven up to 100% reduction of bacterial load and up to 100% increase in shelf life.
Lessons from Mozzarella
Mozzarella provides a clear illustration of the effective application of ozone treatment. During production in some countries, mozzarella is immersed in brine, composed of water, salt, calcium chloride solution and acid. If the brine is not properly filtered, as it is through ozone treatment, it can elevate levels of bacteria such as Pseudomonas aeruginosa or Pseudomonas fluorescens, which cause blue streaks in mozzarella and other products.
Contamination by biofilm present in pipes is another issue, though it often is overlooked in traditional bacterial analysis. Ozone treats and terminates process water contaminated by biofilm. It also prevents the transfer of contaminants that have survived the sanitization process from one tank to the other from compromising the quality of rinsing water used in clean in place cycles.
“The effectiveness of ozone to reduce contamination resulting from the use of water in production processes for the dairy industry has been proven in numerous studies, including those carried out by the Department of Food Science of the University of Udine and by the Institute of Sciences of Food Production of Italy’s National Research Council under the title ‘Use of ozone in the production chain of high moisture Mozzarella cheese’, published in 2013,” Carboni said.
In addition to eliminating the development of unwanted molds, mites and insects such as Piophila Casei, ozone combats Listeria monocytogenes on salted ricotta, gorgonzola, taleggio and other cheeses. As a result, shelf life increases 60%.
Cutting Costs
Another significant concern to those in the dairy industry is the cost of wastewater treatment, particularly if contaminated by biological and chemical products that increase levels of COD, BOD, and micropollutants. Most operators need to reduce those levels before they discharge the wastewater into the municipal treatment system, or before the biological treatment process begins if there is an internal wastewater treatment plant.
Ozone systems reduce COD, BOD and micropollutants, reducing the need for chemical compounds. For example, the use of ozone in a biological purifier can be more effective while reducing sludge production and disposal costs. In fact, when used prior to biological treatment, ozone can reduce COD before the wastewater is introduced into a collection tank.
The data and results gathered from the research led by De Nora and Italian University present a strong case for the use of ozone treatments in the dairy industry. As consumer buying patterns for cheese show no signs of slowing down, ozone presents a sustainable, environmentally-sound solution to ensure food quality and safety while maximizing shelf life.